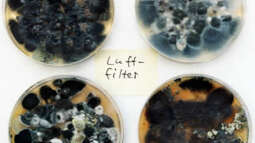

Blog: Was passiert im zugeschlammten Filter wirklich?Ganz Wichtiger Beitrag für Anfänger! (164)
Was passiert im zugeschlammten Filter wirklich, den viele Schreiber als das Beste empfehlen ???
Darin passiert genau das, was wir nicht brauchen, es wird darin nämlich totes organisches Material und damit Gift produziert, weil eine immense Menge sauerstoffbedürftiger Bakterien darin jämmerlich ersticken, während die Mehrzahl nach Sauerstoff schnappend dahin vegetiert. Auch zuviel Filterreinigung verseucht unser Wasser mit abgestorbenen Bakterien und vor allem (falsche Reinigung), indem das Filtermaterial mit (hei??em oder kaltem Wasser ausgewaschen wird). Die dabei vernichteten Bakterien können Sie niemals aus dem Filterschwamm herauswaschen und sie gelangen in das Aquarium, werden zu (Gift).Darum sollte man Filtermaterial auch nur leicht in Aquarienwasser ausdrücken. Was wird aus den anaeroben Bakterien im Wasser, welche von aeroben Bakterien in Filterschwämmen vernichtet werden?
Mit anderen Worten,
ein verschlammter - dreckiger Filter ist ein Guter Filter!
Was bringen wir mit Fischfutter in das Aquarium, welches möglicherweise von toten Tieren zu Mehl gemahlen und dem Futter beigemischt wird ?
Ich würde niemals billiges Fischfutter unbekannter Herkunft, oder No Name verwenden, weil ich wei??, was es bewirken könnte.
Mich Interessiert es wie ihr drüber denkt und wie ihr vorgeht!?